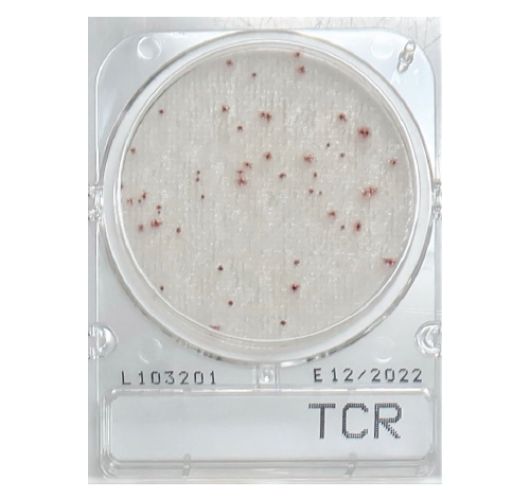

Подложки общее микробное число - Compact Dry TCR
Подложки общее микробное число - Compact Dry TCR (быстрый тест)
Это готовая к использованию среда для подсчета общего количества жизнеспособных микроорганизмов в твердых или жидких образцах пищевых продуктов, гомогенизированных буферным раствором, а также для проведения экологических тестов на основе мазков. Применяется для пищевых продуктов, напитков, фармацевтических и нутрицевтических продуктов.
Обеспечивает количественный подсчет колониеобразующих единиц (КОЕ) на единицу количества микроорганизмов (бактерий, дрожжей и плесени) в образце.
Время инкубации: 24 +/- 2 часа
Температура инкубации:
35 +/- 1°C (AOAC)
32 +/- 1°C (молочные продукты)
Cрок годности: 18 месяцев
Температура хранения: +1°C до +30°C